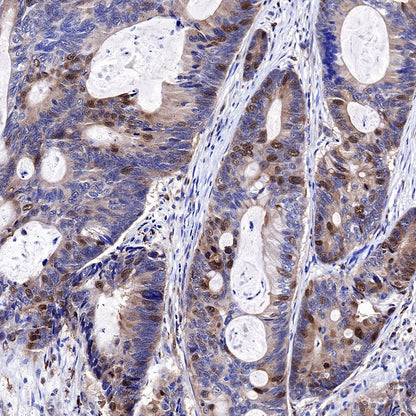

WB result of CDK2 Rabbit mAb
Primary antibody: CDK2 Rabbit mAb at 1/5000 dilution
Lane 1: HeLa whole cell lysate 20 µg
Lane 2: HepG2 whole cell lysate 20 µg
Lane 3: HCT 116 whole cell lysate 20 µg
Secondary antibody: Goat Anti-Rabbit IgG, (H+L), HRP conjugated at 1/10000 dilution
Predicted MW: 34 kDa
Observed MW: 34 kDa
Exposure time: 60s
Product Details
Product Details
Product Specification
| Host | Rabbit |
| Antigen | CDK2 |
| Synonyms | Cyclin-dependent kinase 2, Cell division protein kinase 2, p33 protein kinase, CDKN2 |
| Immunogen | Synthetic Peptide |
| Location | Cytoplasm, Nucleus, Endosome |
| Accession | P24941 |
| Clone Number | SDT-064-40 |
| Antibody Type | Rabbit mAb |
| Application | WB, IHC-P, ICC, IP, ICFCM |
| Reactivity | Hu, Ms, Rt |
| Predicted Reactivity | Hm, Bv |
| Purification | Protein A |
| Concentration | 0.5 mg/ml |
| Physical Appearance | Liquid |
| Storage Buffer | PBS, 40% Glycerol, 0.05% BSA, 0.03% Proclin 300 |
| Stability & Storage | 12 months from date of receipt / reconstitution, -20 °C as supplied |
Dilution
| application | dilution | species |
| WB | 1:5000 | |
| IHC-P | 1:500 | |
| ICFCM | 1:500 | |
| IP | 1:25 | |
| ICC | 1:500 |
Background
Cyclin-dependent kinases (CDKs) are essential kinases that drive cell cycle transformation and transcriptional regulation [PMID: 30185601, PMID: 30375919]. CDKs involve in a variety of biological processes, including cell metabolism, differentiation, and development. Human CDKs are mainly divided into two categories: 1) One group is involved in cell cycle regulation and related to mitosis, and the subtypes are CDK1, 2, 3, 4, and 6. 2) Another group is mainly involved in transcriptional regulation, regulating phosphorylation of RNA polymerase II, and the subtypes are CDK7, 8, 9, and 11 [PMID: 19561645].CDK2 plays a key role in cell cycle regulation [PMID: 14657662, PMID: 30543440, PMID: 30516105]. CDK2 forms a complex with Cyclin E and then phosphorylates Rb, therefore activates E2F [PMID: 24876129]. CDK2-Cyclin A complex promotes cells to pass through the S/G2 checkpoint. CDK2 also controls the phosphorylation of many transcription factors including Smad3 [PMID: 16289004], FoxM1, FoxO1 [PMID: 11250068], NFY, B-Myb [PMID: 14625684], Myc [PMID: 20445224] and promotes the cell cycle. In addition, CDK2 also plays an important role in DNA replication [PMID: 34901021], adaptive immune response, cell differentiation, and apoptosis [PMID: 15617830, PMID: 19561645].
Picture
Picture
Western Blot

FC

Flow cytometric analysis of 4% PFA fixed 90% methanol permeabilized HeLa (Human cervix adenocarcinoma epithelial cell) cells labelling CDK2 antibody at 1/500 (0.1 μg) dilution / (red) compared with a Rabbit monoclonal IgG (Black) isotype control and an unlabelled control (cells without incubation with primary antibody and secondary antibody) (Blue). Goat Anti - Rabbit IgG Alexa Fluor® 488 was used as the secondary antibody.
IP

CDK2 Rabbit mAb at 1/25 dilution (2 µg) immunoprecipitating CDK2 in 0.4 mg HeLa whole cell lysate.
Western blot was performed on the immunoprecipitate using CDK2 Rabbit mAb at 1/1000 dilution.
Secondary antibody (HRP) for IP was used at 1/400 dilution.
Lane 1: HeLa whole cell lysate 10 µg (Input)
Lane 2: CDK2 Rabbit mAb IP in HeLa whole cell lysate
Lane 3: Rabbit monoclonal IgG IP in HeLa whole cell lysate
Predicted MW: 34 kDa
Observed MW: 34 kDa
Exposure time: 10 s
Immunohistochemistry

IHC shows positive staining in paraffin-embedded human colon. Anti-CDK2 antibody was used at 1/500 dilution, followed by a HRP Polymer for Mouse & Rabbit IgG (ready to use). Counterstained with hematoxylin. Heat mediated antigen retrieval with Tris/EDTA buffer pH9.0 was performed before commencing with IHC staining protocol.

IHC shows positive staining in paraffin-embedded human placenta. Anti-CDK2 antibody was used at 1/500 dilution, followed by a HRP Polymer for Mouse & Rabbit IgG (ready to use). Counterstained with hematoxylin. Heat mediated antigen retrieval with Tris/EDTA buffer pH9.0 was performed before commencing with IHC staining protocol.

IHC shows positive staining in paraffin-embedded human tonsil. Anti-CDK2 antibody was used at 1/500 dilution, followed by a HRP Polymer for Mouse & Rabbit IgG (ready to use). Counterstained with hematoxylin. Heat mediated antigen retrieval with Tris/EDTA buffer pH9.0 was performed before commencing with IHC staining protocol.

IHC shows positive staining in paraffin-embedded human colon cancer. Anti-CDK2 antibody was used at 1/500 dilution, followed by a HRP Polymer for Mouse & Rabbit IgG (ready to use). Counterstained with hematoxylin. Heat mediated antigen retrieval with Tris/EDTA buffer pH9.0 was performed before commencing with IHC staining protocol.

IHC shows positive staining in paraffin-embedded human cervical cancer. Anti-CDK2 antibody was used at 1/500 dilution, followed by a HRP Polymer for Mouse & Rabbit IgG (ready to use). Counterstained with hematoxylin. Heat mediated antigen retrieval with Tris/EDTA buffer pH9.0 was performed before commencing with IHC staining protocol.

IHC shows positive staining in paraffin-embedded mouse stomach. Anti-CDK2 antibody was used at 1/500 dilution, followed by a HRP Polymer for Mouse & Rabbit IgG (ready to use). Counterstained with hematoxylin. Heat mediated antigen retrieval with Tris/EDTA buffer pH9.0 was performed before commencing with IHC staining protocol.

IHC shows positive staining in paraffin-embedded rat spleen. Anti-CDK2 antibody was used at 1/500 dilution, followed by a HRP Polymer for Mouse & Rabbit IgG (ready to use). Counterstained with hematoxylin. Heat mediated antigen retrieval with Tris/EDTA buffer pH9.0 was performed before commencing with IHC staining protocol.
Immunocytochemistry

ICC shows positive staining in HeLa cells. Anti-CDK2 antibody was used at 1/500 dilution (Green) and incubated overnight at 4°C. Goat polyclonal Antibody to Rabbit IgG - H&L (Alexa Fluor® 488) was used as secondary antibody at 1/1000 dilution. The cells were fixed with 4%PFA and permeabilized with 0.1% PBS-Triton X-100. Nuclei were counterstained with DAPI (Blue).Counterstain with tubulin (red).